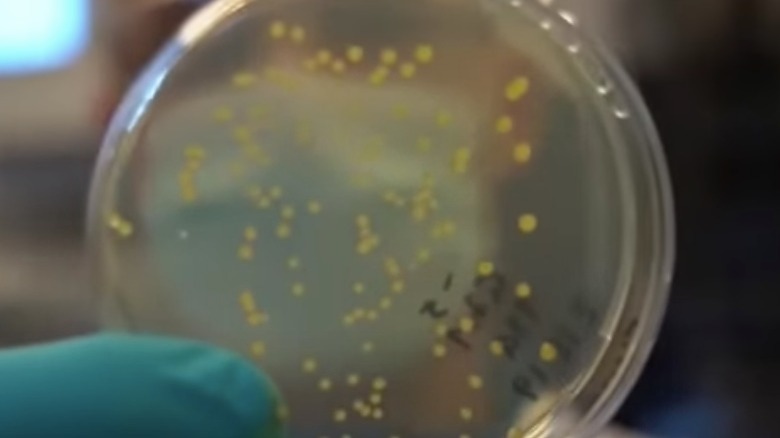
Solein petri dish

Solein: The Marvel Protein Made Out Of Water Molecules
It's difficult to imagine the American diet without conjuring up images of myriad types of meat. Almost all of the meals that are generally associated with the stereotypical American experience are meat-forward — hamburgers, hot dogs, and steak, to name a few. According to the University of Illinois' farmdoc Daily, the average American ate 264 pounds of meat in 2020.
However, there is a steadily growing contingency of Americans who opt to forgo meat altogether. Statista reveals that around 5% of the U.S. population follows a vegetarian diet.
The rise in meat-avoidant diets has opened the market to artificial meat products. We're all familiar with Beyond Meat and Impossible Foods, which you can find in dishes like Panda Express' Beyond Orange Chicken or Burger King's Impossible Whopper (via Business Insider). Another brand, Believer Meats, recently began construction on the largest cultivated meat plant in the world. However, there is one cultivated protein that represents a truly remarkable scientific achievement. It's literally made "out of thin air," per Food Matters Live.
Solein comes from the soil
Though Solar Foods, the company behind this miraculous meat alternative, boasts that their Solein protein is made out of thin air, that is only partially true. Food Matters Live explains that the cultivation process of the protein powder begins when Solein scientists extract a soil sample, which could come from a number of different natural habitats. Then, scientists diligently search the sample to find the microorganisms that are best suited to go through the fermentation process.
The official Solein website explains that after the microorganisms have been selected, they are fed with carbon dioxide and hydrogen particles that are extracted from the water in the air using electricity. It is then given mineral nutrients, which allow it, "to make amino acids, carbohydrates, lipids (fats), and vitamins." After that, any excess moisture is removed from the Solein, which results in a dry powder that is jam-packed with protein. According to the BBC, next to no greenhouse gasses are produced during this process.
Solar Foods and Solein
Food Matters Live tells us that Solar Foods was founded in 2017, and since, it has accrued about $60 million in investments, as well as racking up a laundry list of different technology awards.
In an interview with TechCrunch, Dr. Pasi Vainikka, Solar Foods' co-founder and CEO, explains that the innovative powder has a nutritional makeup that resembles something like dried meat, dried carrot, or dried soy. The product is a whopping 65% protein. He also notes that Solein's flavor is quite mild.
Due to its mild taste, Solein can be included in any number of foods. The Solein website highlights its potential uses, which include transforming it into a meat alternative; combining it with carbohydrates like cereal, bread, and pasta; or simply adding it to snacks or beverages. The Solar Foods YouTube channel has many videos that showcase how the powder can be used to craft your next delicious meal.